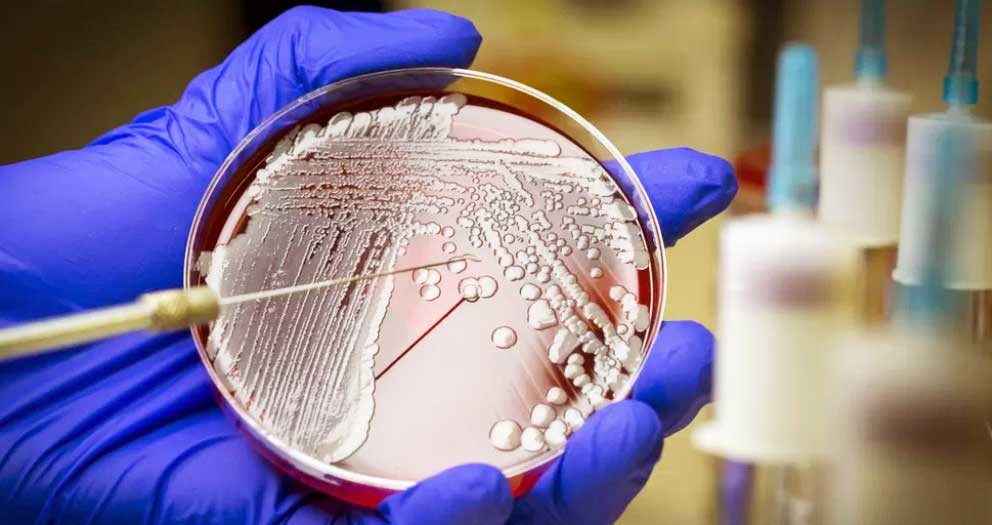

NIEUW SUPERBACTERIE DODEND ANTIBIOTICUM ONTDEKT MET BEHULP VAN AI
Foto: Wetenschapper Denise Catacutan werkt aan het experimentele antibioticum ontdekt met behulp van kunstmatige intelligentie | James Gallagher | BBC
Wetenschappers hebben kunstmatige intelligentie (AI) gebruikt om een nieuw antibioticum te ontdekken dat een dodelijke superbacterie kan doden.
De AI hielp duizenden potentiële chemicaliën terug te brengen tot een handvol dat in het laboratorium kon worden getest. Het resultaat was een krachtig, experimenteel antibioticum, abaucin genaamd, dat nog verder moet worden getest voordat het kan worden gebruikt. Volgens onderzoekers in Canada en de VS kan AI de ontdekking van nieuwe geneesmiddelen enorm versnellen. Het is het nieuwste voorbeeld van hoe de instrumenten van kunstmatige intelligentie een revolutionaire kracht kunnen zijn in de wetenschap en de geneeskunde.
Antibiotica doden bacteriën. Er is echter al tientallen jaren een gebrek aan nieuwe geneesmiddelen en bacteriën zijn steeds moeilijker te behandelen omdat ze resistentie ontwikkelen tegen de geneesmiddelen die we hebben. Naar schatting sterven meer dan een miljoen mensen per jaar aan infecties die de behandeling met antibiotica weerstaan.
De onderzoekers richtten zich op een van de meest problematische soorten bacteriën – Acinetobacter baumannii, die wonden kan infecteren en longontsteking kan veroorzaken. U hebt er misschien nog nooit van gehoord, maar het is een van de drie superbacteriën die door de Wereldgezondheidsorganisatie zijn aangemerkt als een “kritieke” bedreiging. Ze kan vaak meerdere antibiotica weerstaan en vormt een probleem in ziekenhuizen en verzorgingstehuizen, waar ze kan overleven op oppervlakken en medische apparatuur. Dr. Jonathan Stokes van de McMaster University beschrijft de bacterie als “volksvijand nummer één” omdat het “heel gewoon” is om gevallen te vinden waarbij de bacterie “resistent is tegen bijna elk antibioticum”.

Dr. Jonathan Stokes van de McMaster University
Om een nieuw antibioticum te vinden, moesten de onderzoekers eerst de AI trainen. Ze namen duizenden geneesmiddelen waarvan de precieze chemische structuur bekend was en testten die handmatig op Acinetobacter baumannii om te zien welke de bacterie konden afremmen of doden.
Deze informatie werd aan de AI doorgegeven, zodat deze de chemische kenmerken kon leren van geneesmiddelen die de problematische bacterie konden aanvallen. De AI werd vervolgens losgelaten op een lijst van 6.680 verbindingen waarvan de doeltreffendheid onbekend was. Uit de resultaten – gepubliceerd in Nature Chemical Biology – bleek dat de AI anderhalf uur nodig had om een shortlist op te stellen. De onderzoekers testten er 240 in het laboratorium en vonden negen potentiële antibiotica. Een daarvan was het ongelooflijk krachtige antibioticum abaucine. Laboratoriumexperimenten toonden aan dat het geïnfecteerde wonden bij muizen kon behandelen en A. baumannii monsters van patiënten kon doden.
Echter, Dr. Stokes gaf aan: “Dat het werk nu pas begint.” De volgende stap is om het geneesmiddel in het laboratorium te perfectioneren en vervolgens klinische proeven uit te voeren. Hij verwacht dat het tot 2030 kan duren voordat de eerste AI-antibiotica beschikbaar zijn om te worden voorgeschreven. Vreemd genoeg had dit experimentele antibioticum geen effect op andere soorten bacteriën en werkt het alleen op A. baumannii.
Bacteriën die in het laboratorium worden gekweekt
Veel antibiotica doden bacteriën zonder onderscheid. De onderzoekers denken dat de precisie van abaucin het moeilijker zal maken voor het ontstaan van geneesmiddelenresistentie en kan leiden tot minder bijwerkingen. In principe zou de AI tientallen miljoenen potentiële verbindingen kunnen screenen – iets wat onpraktisch zou zijn om handmatig te doen. “Deze bevinding ondersteunt het uitgangspunt dat AI onze zoektocht naar nieuwe antibiotica aanzienlijk kan versnellen en uitbreiden”, aldus professor James Collins van het Massachusetts Institute of Technology. Hij voegde eraan toe: “Ik ben blij dat dit werk laat zien dat we AI kunnen gebruiken om problematische ziekteverwekkers zoals A. baumannii te bestrijden.”
UNITEDNEWS | WETENSCHAP

